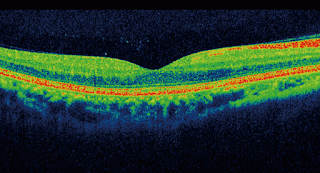
Glaucoma y nuevas tecnologías.

La campimetría o examen del campo visual, ha sido durante mucho tiempo el patrón de referencia para evaluar el estado del glaucoma.
La campimetría mide la función visual y detecta la pérdida de la visión periférica causada por el daño al nervio óptico.
La pérdida del campo visual es la manifestación clínica del glaucoma avanzado y su progresión indica que el tratamiento no está funcionando.
Pero la pérdida del campo visual se manifiesta cuando se han perdido entre el 30 y 50% de las fibras nerviosas del nervio óptico, es decir que en los estado iniciales de la enfermedad, la campimetría no detectará cambios en la visión.
Con la llegada de la Tomografía de Coherencia Óptica (OCT) se puede analizar la estructura del nervio óptico y la capa de fibras nerviosas de la retina con bastante precisión.
La OCT, que es una tecnología no ivasiva, puede medir el adelgazamiento de la capa de fibras nerviosas y el daño en el nervio óptico mucho antes de que los cambios se traduzcan en una pérdida funcional que pueda detectar la campimetría.
A diferencia de la campimetría que depende de la respuesta del paciente, la OCT cuantifica objetivamente el daño.
Ambas pruebas se complementan para el control del glaucoma.
La OCT es crucial para el diagnóstico precoz ya que identifica el daño anatómico; y la campimetría es esencial para evaluar el impacto funcional de la enfermedad y para el seguimiento en estados avanzados.
Referencia
Imagen de Yandex
